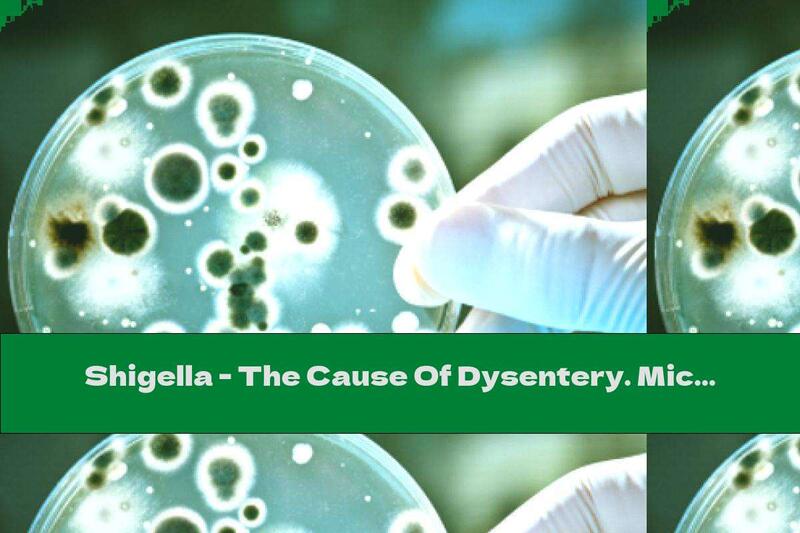
Shigella - The Cause Of Dysentery. Microbiology

Cause Topic - Related Articles - Page 3

7 Foods And Beverages That Cause Heartburn
In this article, learn more about 7 Foods And Beverages That Cause Heartburn. Stomach acids affect 1/3 of the Bulgarian population..
Read more →
Non-alcoholics Can Cause Arrhythmia
Regular and excessive consumption of soft drinks leads to a pronounced loss of potassium, which is the cause of life-threatening arrhythmias.
Read more →
Foods That Cause High Cholesterol
Learn more information about foods that cause high cholesterol. In this article we'll discuss foods that cause high cholesterol.
Read more →
Do Statins Cause Dementia
Learn more information about do statins cause dementia. In this article we'll discuss do statins cause dementia.
Read more →
Foods That Cause Cholesterol
Learn more information about foods that cause cholesterol. In this article we'll discuss foods that cause cholesterol.
Read more →
The Cause Of Obesity Lies In Chromosome 16.
Severe obesity is caused by a lack of genetic information on chromosome sixteen.
Read more →
Shigella - The Cause Of Dysentery. Microbiology
In this article, learn more about Shigella - The Cause Of Dysentery. Microbiology. Microbiological diagnosis is essential.
Read more →
Foods That Cause Inflammation
Learn more information about foods that cause inflammation. In this article we'll discuss foods that cause inflammation.
Read more →
Artificial Sweeteners Can Cause Diabetes
The composition of intestinal bacteria is crucial for the metabolic health of the body.
Read more →
Heartburn - What Can They Cause Us And How To Avoid Them?
In this article, learn more about Heartburn - What Can They Cause Us And How To Avoid Them?. Acids are not always harmless. What measures to take to prevent them..
Read more →Top Nutrition Articles Today
- . Being Vegan
- . Nutrition and Muscular Dystrophy: Supporting Muscle Strength...
- . Diet For Biliary Tract Dyskinesia
- . The Role of Additives in Nutrition: Positive and Negative Ef...
- . Metamucil Cholesterol
- . Nutrition In Chronic Cholecystitis
- . Iso Sensation Protein
- . Carbs to Sugar Conversion Chart: Monitoring Carb and Sugar I...
- . Ammonium Bicarbonate: Benefits, Uses, and Considerations for...
- . The Role of K12 in Nutrition: Benefits, Sources, and Recomme...